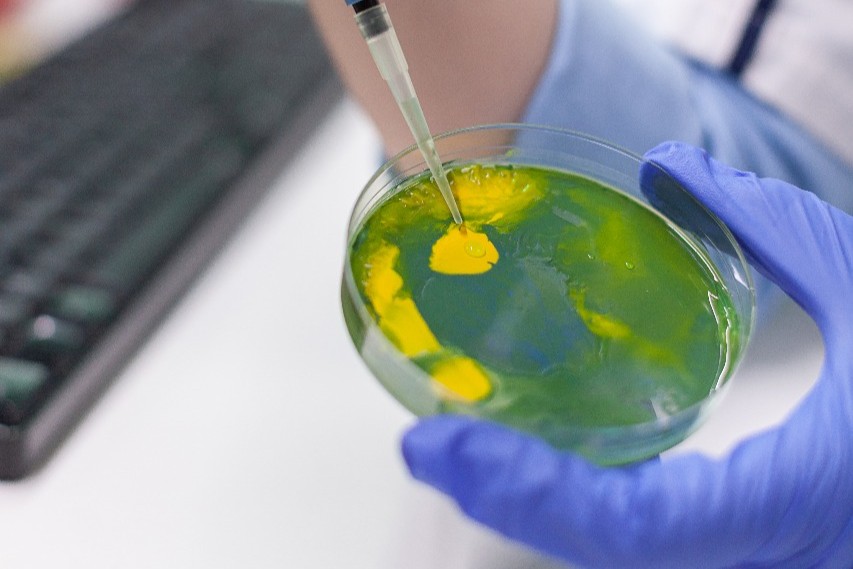
Storage & Handling

PT. UNIVERSAL LABORA ANALITIKA
Laboratory Instrument, Process Control, and Chemicals
PT. UNIVERSAL LABORA ANALITIKA
Laboratory Instrument, Process Control, and Chemicals
(+62-21) 88851716
info@ula.co.id
(+62-21) 88868955
© 2026 Universal Labora Analitika | All Rights Reserved